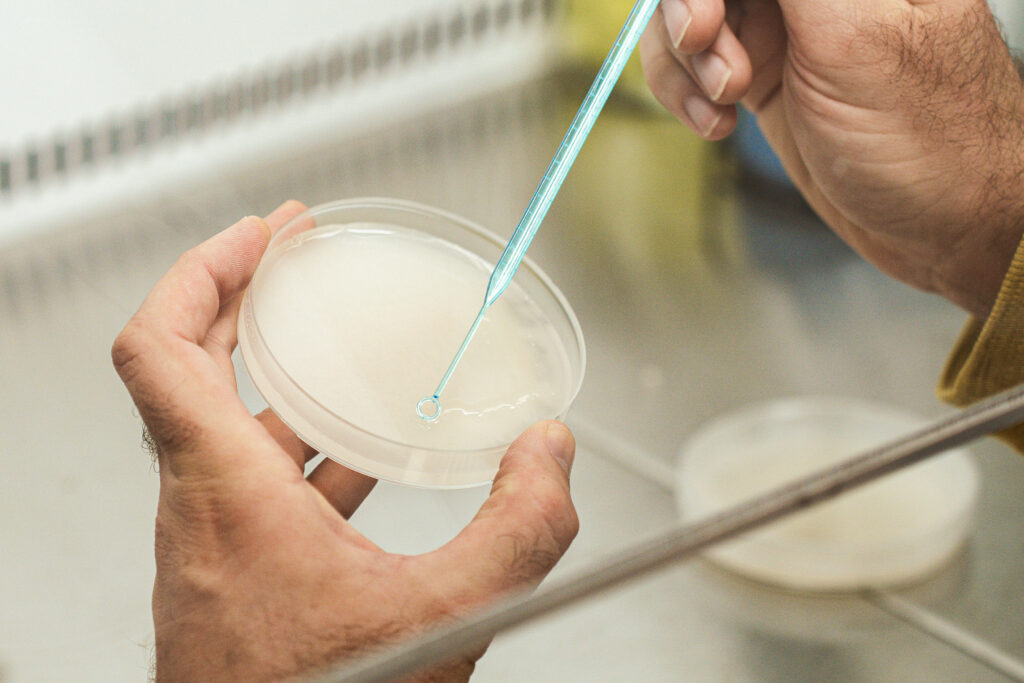

Technologie Bacter-Perf-WP
Augmenter les rendements des cultures et protéger, préserver et régénérer la santé et la vie des sols.
La technologie Bacter-Perf-WP constitue le cœur de notre gamme de biostimulants microbiens. Elle inclut les solutions N1TRIUM, A6MIL, K4LIBRE et D3STRESS. Ces solutions se présentent en poudre hydrosoluble. Elles s’appliquent facilement au sol par pulvérisation, en enrobage de semences ou avec des engrais.
Cette technologie s’intègre simplement aux itinéraires techniques existants. Elle agit directement au niveau du sol et des racines. Elle optimise la nutrition des plantes, stimule leur développement et soutient durablement la fertilité des sols.
En 2018, nous avons lancé nos premiers travaux sur l’identification des micro-organismes de notre principe actif Ov. Ov bénéficie d’une réputation établie pour son fort pouvoir fertilisant. Nous avons mené ces travaux avec le Muséum national d’Histoire naturelle de Paris. Le professeur Marc-André Selosse a participé à cette collaboration scientifique. Nous avons identifié 374 espèces de champignons et 234 espèces de bactéries.
Au sein de cette biodiversité exceptionnelle, nous avons sélectionné des micro-organismes robustes. Nous les multiplions grâce à un procédé unique de biofermentation solide. Ce procédé reste spécifique et propre à OvinAlp.
Une technologie microbienne au service du sol et des cultures
Les biostimulants microbiens issus de la technologie Bacter-Perf-WP ont été rigoureusement sélectionnés et identifiés au sein de notre principe actif Ov pour leur capacité à améliorer significativement la production des cultures agricoles. Leur action repose sur une approche globale du sol et de la plante, en intervenant à plusieurs niveaux complémentaires.
Ils contribuent à optimiser les réserves du sol, à faciliter l’assimilation des éléments minéraux par les plantes et à renforcer leur capacité à faire face aux aléas climatiques. En stimulant l’activité biologique du sol, ils participent à la préservation de sa structure, de sa vitalité et de son équilibre naturel, conditions essentielles à des rendements durables.

Une action ciblée au niveau racinaire
La technologie Bacter-Perf-WP agit principalement au niveau racinaire, là où tout commence. En favorisant l’activité des micro-organismes bénéfiques, ces biostimulants permettent de libérer les éléments fertilisants biodisponibles, notamment dans les sols dits « bloqués ».
Cette stimulation racinaire améliore la nutrition des plantes et renforce leur vigueur. Elle soutient leur développement tout au long du cycle cultural. En restaurant certaines fonctions biologiques essentielles, la technologie Bacter-Perf-WP redonne au sol son rôle naturel. Elle contribue à un fonctionnement performant et équilibré du système sol-plante.
Des bénéfices agronomiques durables
Grâce à leur mode d’action microbien, les solutions issues de la technologie Bacter-Perf-WP permettent de :
- améliorer l’efficacité de la nutrition des cultures,
- accompagner les plantes face aux stress climatiques et environnementaux,
- préserver et régénérer la vie biologique des sols,
- sécuriser et optimiser les rendements sur le long terme.
Cette technologie s’inscrit pleinement dans une agriculture plus durable, où la performance agronomique repose sur des sols vivants, fonctionnels et résilients.
Une gamme de solutions adaptées aux besoins des cultures
Déployée à travers les produits N1TRIUM, A6MIL, K4LIBRE et D3STRESS, la technologie Bacter-Perf-WP offre des réponses ciblées aux différents enjeux nutritionnels et physiologiques des cultures, tout en conservant une base commune : stimuler le sol pour mieux nourrir la plante.